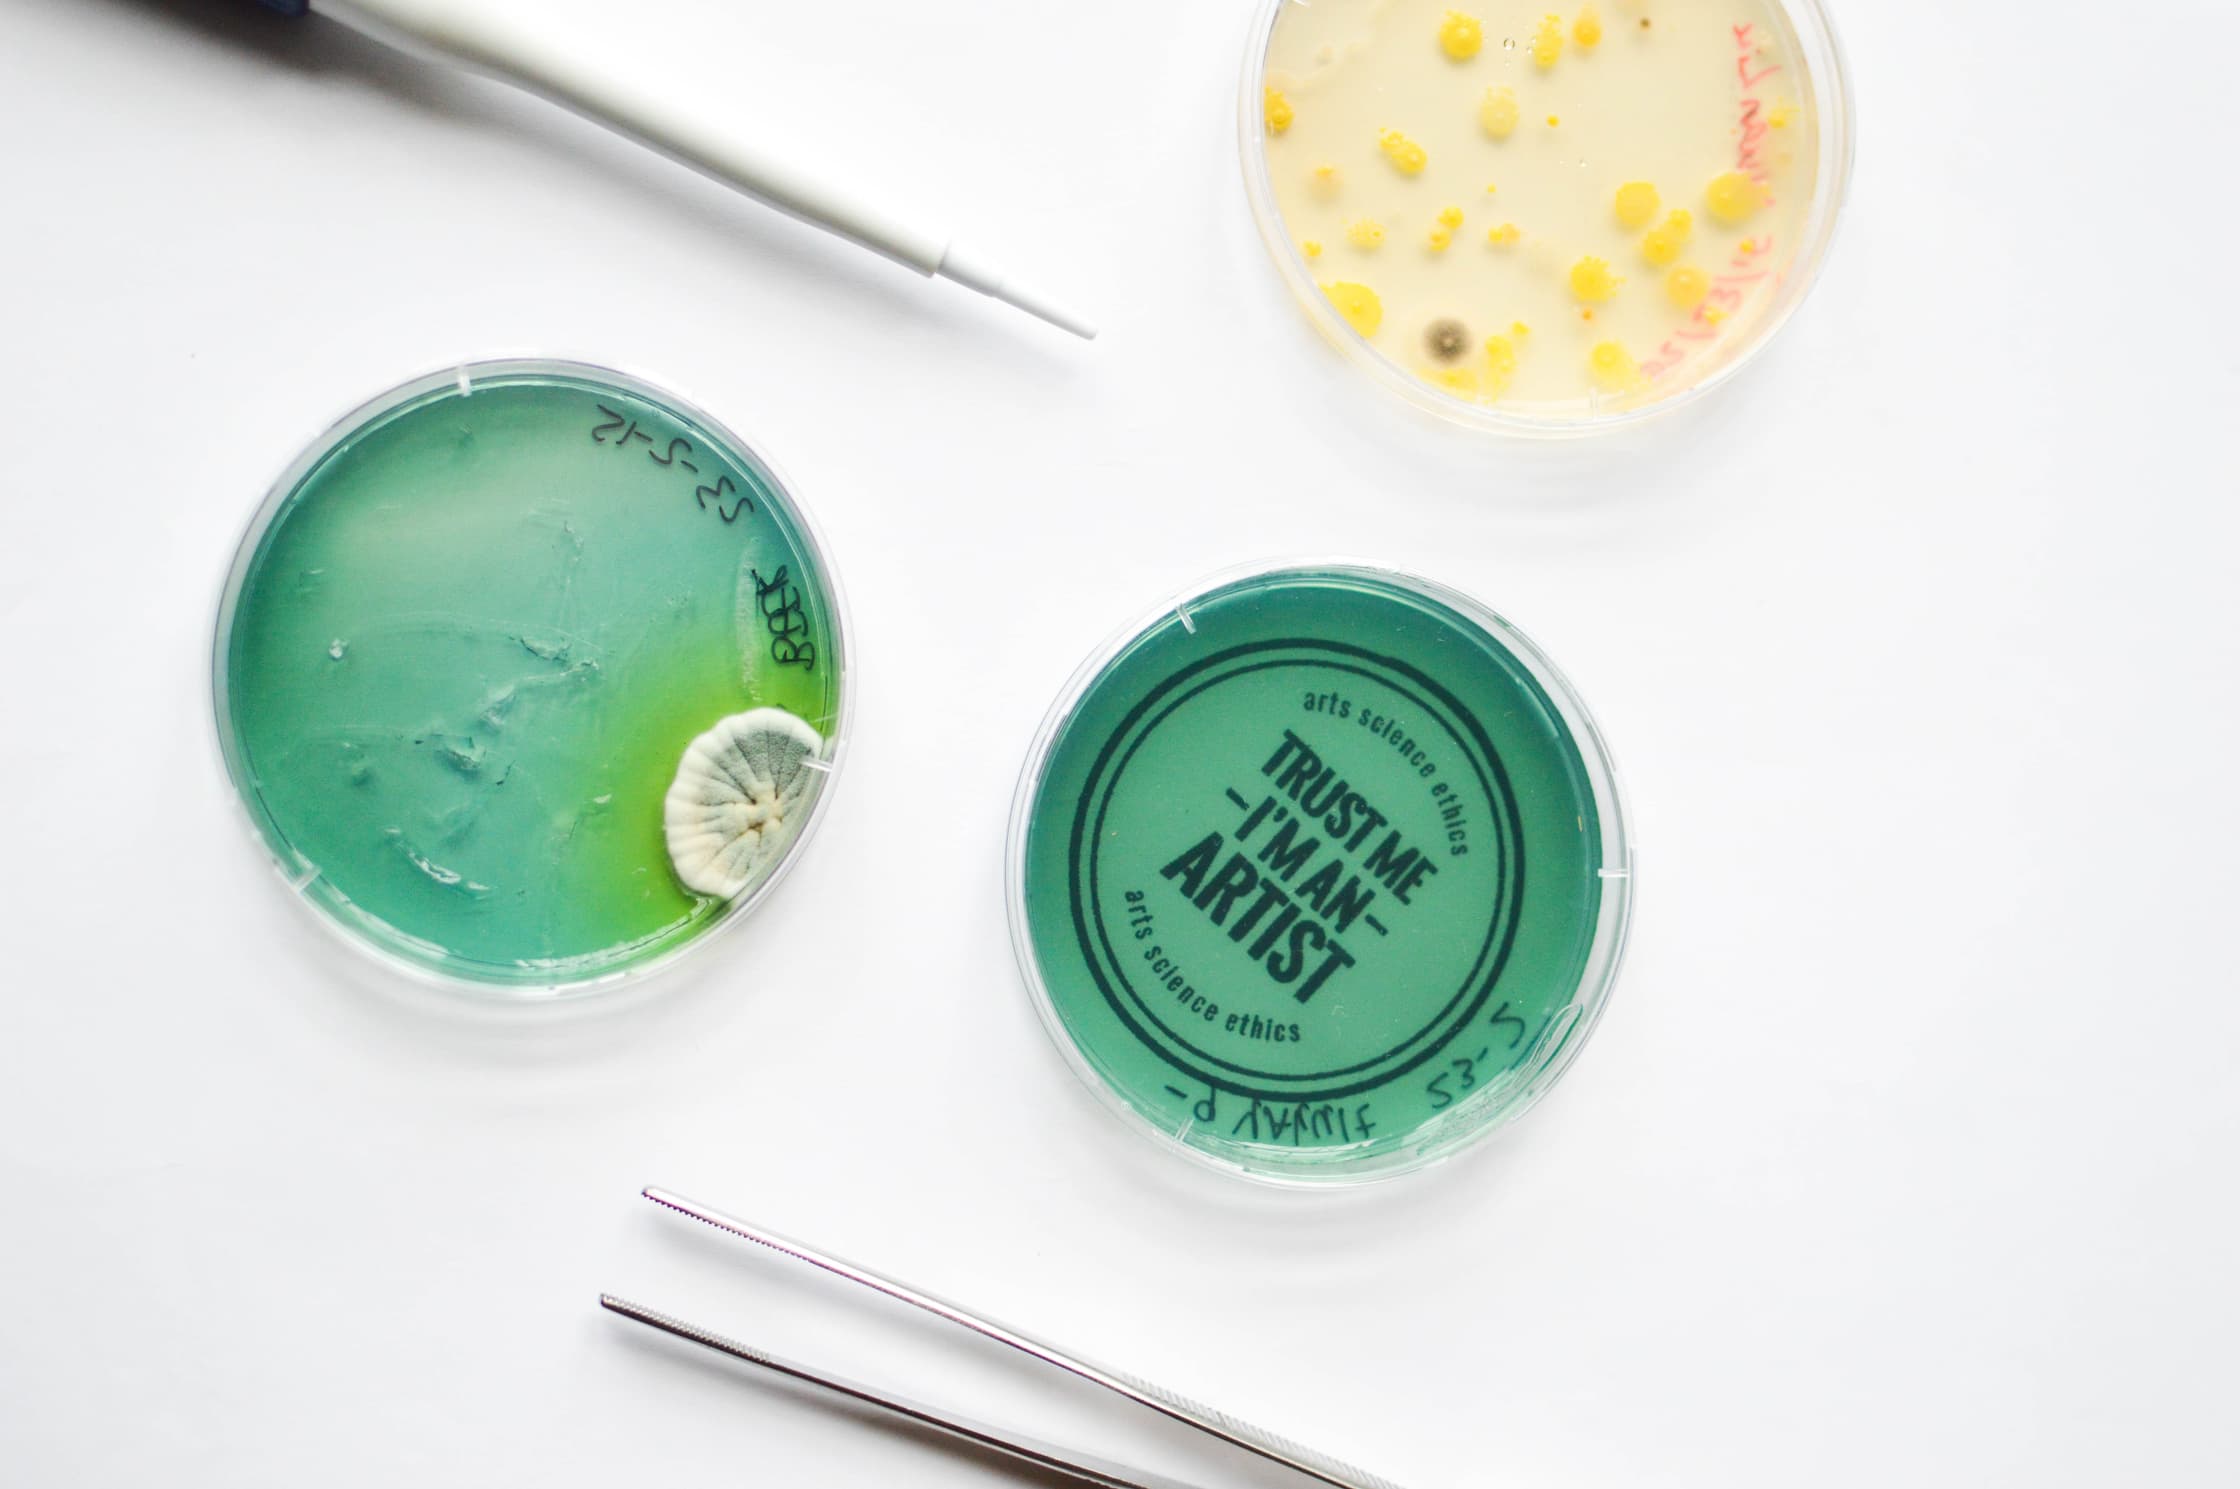

make
Vanuit haar wortels in de hackersbeweging is Waag ervan overtuigd dat we als mensen (bijna) alles kunnen maken met behulp van digitale fabricage, open-source hardware en het delen van kennis. Make richt zich op deze (on)maakbaarheid, met technologie, biotechnologie, textiel en ecologie als focusgebieden. Er wordt onderzoek gedaan naar materiaal, materiaalstromen, maak- en productieprocessen, hun sociale en ecologische betekenissen en hun betekenis voor de toekomst. Daarbij werken we veel samen met en bieden we onderdak aan ontwerpers en kunstenaars die zich op het snijvlak van kunst, technologie en wetenschap begeven.